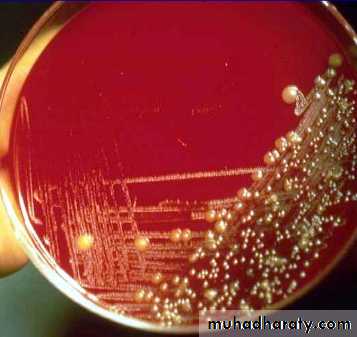

Fifth stage
pediatricsLec-15
Dr. Athal Humo
30/11/2015
PneumoniaDefinition:
Pneumonia is an infection of the lower respiratory tract that involves the airways and parenchyma with consolidation of the alveolar spaces.
Lobar pneumonia describes pneumonia localized to one or more lobes of the lung.
Bronchopneumonia refers to inflammation of the lung that is centered in the bronchioles and leads to the production of a mucopurulent exudate that obstructs some of these small airways and causes patchy consolidation of the adjacent lobules.
Atypical pneumonia describes patterns typically more diffuse or interstitial than lobar pneumonia.
ETIOLOGY :
ETIOLOGY
§ : H. influenzae type b infection is uncommon with universal H. influenzae type b immunization.
*: other respiratory viruses (parainfluenza viruses, influenzaviruses, adenoviruses, human metapneumovirus.
Additional agents causes of pneumonia:
SARS (severe acvute respiratory syndrome): due to corona virus.
Avian influenza (bird flu): is highly contagious viral disease of poultry & other birds caused by influenza A (H5N1). There were outbreaks among humans in South East Asia in 1997 & 2003-2004 with high mortality rate.
A novel influenza A (H1N1) of swine origin began circulating in 2009.
M. pneumoniae and Chlamydophila pneumoniae are principal causes of atypical pneumonia.
Causes of pneumonia in immunocompromised persons include:
gram-negative enteric bacteria
mycobacteria (M. avium complex)
fungi (aspergillosis)
viruses (CMV)
Pneumocystis carinii
Pneumonia in patients with cystic fibrosis usually is caused by:
Staphylococcus aureus in infancy
Pseudomonas aeruginosa or Burkholderia cepacia in older patients.
Risk factors for lower respiratory tract infections include:
GERD
Neurologic impairment (aspiration)
Immunocompromised states.
Anatomic abnormalities of the respiratory tract.
Hospitalization, especially in an intensive care unit (ICU) or requiring invasive procedures.
CLINICAL MANIFESTATIONS
Fever, chills, tachypnea, cough, malaise, pleuritic chest pain, retractions, SOB & apprehension. Apnea especially in young infant.
Examination cannot distinquish viral from bacterial pneumonia, in general:
Viral pneumonias: are associated more often with cough, wheezing, or stridor; low fever. Hyperexpansion cause low diaphragm or liver. Sign of consolidation diffuse.
Bacterial pneumonias: typically are associated with higher fever, chills, cough, dyspnea, and findings of lung consolidation localized (bronchial breathing, dull percussion, distant breath sound & course crepitation). Poor diaphragmatic excursion may indicate large consolidation or effusion.
LABORATORY AND IMAGING STUDIES
WBC: in viral pneumonias is often normal or mildly elevated, with a predominance of lymphocytes, whereas with bacterial pneumonias the WBC count is elevated (>20,000/mm3) with a predominance of neutrophils.
Blood cultures are positive in 10% to 20% of bacterial pneumonia.
Viral detection: by serology or culture, but not routine.
M. pneumoniae: Mycoplasma IgM or PCR.
M. tuberculosis: is established by tuberculin skin test, and analysis of sputum or gastric aspirates by culture or PCR.
When there is effusion or empyema, performing a thoracentesis to obtain pleural fluid can be diagnostic and therapeutic.
The need to establish an etiologic diagnosis of pneumonia are:
immunocompromised patients
recurrent pneumonia
pneumonia unresponsive to empirical therapy.
For these patients:
bronchoscopy with bronchoalveolar lavage and brush mucosal biopsy, needle aspiration of the lung, and open lung biopsy are methods of obtaining material for microbiologic diagnosis.
Lobar Pneumonia
Bronchopneumonia
Mycoplasma pneumoniae infection (atypical pneumonia)
CXR:
Frontal & lateral:
Bacterial pneumonia characteristically shows lobar consolidation, or a round pneumonia, with pleural effusion in 10% to 30% of cases.
Viral pneumonia characteristically shows diffuse, streaky infiltrates of bronchopneumonia.
Atypical pneumonia, such as with M. pneumoniae and C. pneumoniae, shows increased interstitial markings or bronchopneumonia.
Decubitus views to assess size of pleural effusions.
Ultrasound: to assess pleural effusions.
CT: is used to evaluate serious disease, abscesses & effusions.
TREATMENT
Therapy for pneumonia includes supportive and specific treatment and depends on the degree of illness, complications, and knowledge of the infectious agent likely causing the pneumonia.
Factors Suggesting Need for Hospitalization :
Age <6 months with suspected bacterial pneumonia.
Immunocompromised state
Toxic appearance
Severe respiratory distress
Requirement for supplemental oxygen
Dehydration
Vomiting
No response to appropriate oral antibiotic therapy.
Suspect pathogen with increased virulence e.g. methicillin resistant staph aureus.
Noncompliant parents
Outpatients treatment: 7-10 days
Amoxicillin
Erythromycin, azithromycin, or clarithromycin if atypical pn. suspected.
Hospital treatment: 10-14 days
Usually combined antibiotic therapy according to age & suspected organism.
Neonate: treated as sepsis
< 5 yeasr:
Amoxicillin or ampicillin (if fully immunized for s. pneumoniae & H. influenzae type b). Alternative: cefotaxime or ceftriaxone if not fully immunized or local pencillin resistant.
Plus clindamycin
Plus macrolide if atypical pneumonia suspected.
> 5 yeasr:
Ampicillin
Plus macrolide if atypical pneumonia suspected.
Treatment in the ICU: 10-14 days
Intravenous administration for inpatients except for the macrolides (erythromycin, azithromycin, and clarithromycin), which are given orally.
< 5 yeasr:
Cefotaxime or ceftriaxone
Plus nafcillin , oxacillin, clindamycin or vancomycin.
Plus macrolide if atypical pneumonia suspected.
> 5 yeasr:
Cefuroxime or ceftriaxone
Plus macrolide if atypical pneumonia suspected.
With or without clindamycin or vancomycin.
COMPLICATIONS AND PROGNOSIS
Parapneumonic effusion
Empyema
Lung abscess
Pneumatocele
Bronchiectasis
Bronchiolitis obliterans: due to severe adenovirus pneumonia, inflammatory process in which the small airways are replaced by scar tissue, resulting in a reduction in lung volume and lung compliance.
PREVENTION
Annual influenza vaccine is recommended for all children over 6 mo.
Universal childhood vaccination with conjugate vaccines for H influenzae type b and S. pneumoniae.
The severity of RSV infections can be reduced by use of palivizumab in high-risk patients.
Reducing the duration of mechanical ventilation and administering antibiotics judiciously reduces the incidence of ventilator-associated pneumonias.
The head of the bed should be raised to 30 to 45 degrees for intubated patients to minimize risk of aspiration, and all suctioning equipment and saline should be sterile.
Hand washing before and after every patient contact and use of gloves for invasive procedures are important measures to prevent nosocomial transmission of infections.
Hospital staff with respiratory illnesses or who are carriers of certain organisms, such as methicillin-resistant S. aureus, should comply with infection control policies to prevent transfer of organisms to patients.
Most children recover from pneumonia rapidly and completely, although radiographic abnormalities may take 6 to 8 weeks to return to normal.
In a few children, pneumonia may persist longer than 1 month or may be recurrent. In such cases, the possibility of underlying disease must be investigated further, such as:
Tuberculin skin test
sweat chloride determination for cystic fibrosis
serum Ig and IgG subclass determinations
Bronchoscopy to identify anatomic abnormalities or foreign body
Barium swallow for GERD.
Differential Diagnosis of Recurrent Pneumonia
(PERTUSSIS )
Classic pertussis, whooping cough, is caused by B. pertussis, a gram-negative pleomorphic bacillus with fastidious growth requirements.
B. pertussis infect only humans and are transmitted person to person by coughing.
The incubation period is 7-10 days. Patients are most contagious during the first 2 weeks of cough.
The peak age incidence of pertussis in the US is < 4 months of age-among infants too young to be completely immunized and most likely to have the severe complications.
Infections in adolescents have also been rising, likely due to waning immunity from previous vaccines.
CLINICAL MANIFESTATIONS
The progression of the disease is divided into catarrhal, paroxysmal, and convalescent stages.The catarrhal stage: is marked by nonspecific signs (increased nasal secretions, and low-grade fever) lasting 1 to 2 weeks.
The paroxysmal stage: is the most distinctive stage of pertussis and lasts 2 to 4 weeks. Coughing occurs in paroxysms during expiration, causing young children to lose their breath. This pattern of coughing is needed to dislodge plugs of necrotic bronchial epithelial tissues and thick mucus. The forceful inhalation against a narrowed glottis that follows this paroxysm of cough produces the characteristic whoop. Post-tussive emesis is common.
The convalescent stage: is marked by gradual resolution of symptoms over 1 to 2 weeks. Coughing becomes less severe, and the paroxysms and whoops slowly disappear. Although the disease typically lasts 6 to 8 weeks, residual cough may persist for months, especially with physical stress or respiratory irritants.
Infants may not display the classic pertussis syndrome. The first sign in the neonate may be episodes of apnea. Young infants are unlikely to have the classic whoop, more likely to have CNS damage as a result of hypoxia, and more likely to have secondary bacterial pneumonia.
LABORATORY AND IMAGING STUDIES
Isolation of B. pertussis by culture on specialized media.
PCR
Lymphocytosis: is present in 75% to 85% of patients but not diagnostic. WBC increase to to more than 50,000 cells/mm3, consisting primarily of mature lymphocytes.
CXR: segmental lung atelectasis. Perihilar infiltrates are common and are similar to what is seen in viral pneumonia.
"shaggy heart" on CXR in a patient with Bordetella pertussis pneumonia.
\
TREATMENT
Macrolide are recommended for children under 1 month of age. Azithromycin should be used in neonates due to the association of erythromycin treatment and the development of pyloric stenosis.
Early treatment eradicates nasopharyngeal carriage of organisms within 3 to 4 days and lessens the severity of symptoms.
Treatment in the paroxysmal stage does not alter the course of illness but decrease the potential for spread to others.
TMP-SMZ is an alternative therapy among children >2mo, but this remains unproved.
COMPLICATIONS AND PROGNOSIS
Major complications are most common among infants and young children and include:
Hypoxia
Apnea
Pneumonia (caused by B. pertussis itself or resulting from secondary bacterial infection)
Atelectasis may develop secondary to mucous plugs.
The force of the paroxysm may produce pneumomediastinum, pneumothorax, or interstitial or subcutaneous emphysema; epistaxis; hernias; and retinal and subconjunctival hemorrhages.
Otitis media and sinusitis may occur.
Seizures
Encephalopathy
Malnutrition.
Most children do well with complete healing of the respiratory epithelium and have normal pulmonary function after recovery. Young children can die from pertussis and are more likely to be hospitalized than older children. Most permanent disability is a result of encephalopathy.
PREVENTION
Active immunity is induced with acellular pertussis components given in combination with the tetanus and diphtheria toxoids (DTaP ).
Macrolides are effective in preventing secondary cases in contacts exposed to pertussis.
Under immunized close contacts under 7 years of age should receive a booster dose of DTaP (unless a booster dose has been given within the preceding 3 years), where as those 7-10 years of age should receive Tdap.
All close contacts should receive prophylactic antibiotic for 5 days (azithromycin) or 7 to 14 days (clarythromcin or erythromycin)